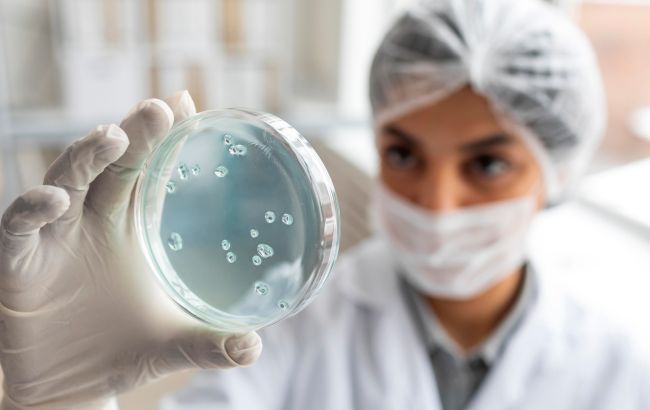
Підрив ГЕС. У постраждалих регіонах відкрили пункти зі швидкими тестами на холеру

Підрив ГЕС. У постраждалих регіонах відкрили пункти зі швидкими тестами на холеру
Фото: в Херсонській області створили хаби з тестами на холеру (freepik.com)
Фото: в Херсонській області створили хаби з тестами на холеру (freepik.com)
У постраждалих внаслідок підриву Каховської ГЕС районах відкрили інфекційні хаби, які забезпечені швидкими тестами для діагностики холери. Звернутись можуть пацієнти з інфекційними хворобами.
Про це повідомляє РБК-Україна з посиланням на заяву Міністерства охорони здоров'я України.
Інфекційні хаби розгорнули у лікарнях на території Миколаївської, Херсонської та Дніпропетровської областей. В них прийматимуть пацієнтів з гострими кишковими й іншими інфекційними хворобами.
"У визначених медзакладах вже розгорнули додаткові ліжка для пацієнтів", - заявили в МОЗ.
Наразі всі хаби отримали препарати, які необхідні для швидкої діагностики та лікування холери.
На сьогодні, за даними міністерства, епідеміологічна ситуація на постраждалих територіях прогнозована та керована. На території областей, які зазнали підтоплення, посилено епідеміологічний нагляд. В Одеській, Миколаївській і Херсонській областях сформовано 38 точок моніторингу води поверхневих водойм вздовж річища та морського узбережжя.
За підсумками проведених досліджень, вода, яка централізовано подається або підвозиться населенню, а також бутильована вода, відповідає Державним санітарним правилам та нормам і є безпечною для споживання.
В МОЗ пояснили, що за необхідності, якщо в Херсонській області бракуватиме медиків певної спеціалізації, залучатимуться спеціалісти з інших областей.
Ймовірність вияву холери в Україні
Через підрив Каховської ГЕС у воду потрапили пально-мастильні матеріали та отрутохімікати. Через це у Херсонській області фіксують наявності в воді холерної та кишкової палички.
Варто зазначити, що воду з криниць можна буде вживати тільки після того, як їх прочистять і перевірять зразки в лабораторії.
За інформацією МОЗ, в Україні не зафіксували спалаху інфекційних хвороб після підриву російськими окупантами Каховської ГЕС.
Зазначається, що контроль за епідемічною ситуацією в підтоплених районах Херсону та області проводиться щоденно.
Термінові та важливі повідомлення про війну Росії проти України читайте на каналі РБК-Україна в Telegram.


